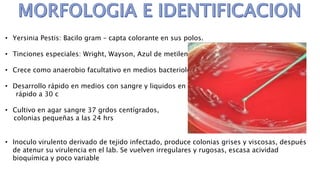
• Yersinia Pestis: Bacilo gram – capta colorante en sus polos.
• Tinciones especiales: Wright, Wayson, Azul de metileno, Giemsia.
• Crece como anaerobio facultativo en medios bacteriológicos.
• Desarrollo rápido en medios con sangre y liquidos en tejidos,
rápido a 30 c
• Cultivo en agar sangre 37 grdos centígrados,
colonias pequeñas a las 24 hrs
• Inoculo virulento derivado de tejido infectado, produce colonias grises y viscosas, después
de atenur su virulencia en el lab. Se vuelven irregulares y rugosas, escasa acividad
bioquímica y poco variable

Este documento describe Yersinia pestis, el bacilo que causa la peste. Se transmite principalmente de roedores a humanos a través de la picadura de pulgas infectadas. Puede causar bubones, sepsis y neumonía potencialmente mortales. Su diagnóstico requiere cultivos y análisis de muestras de sangre u otros tejidos, y su tratamiento incluye antibióticos como la estreptomicina.